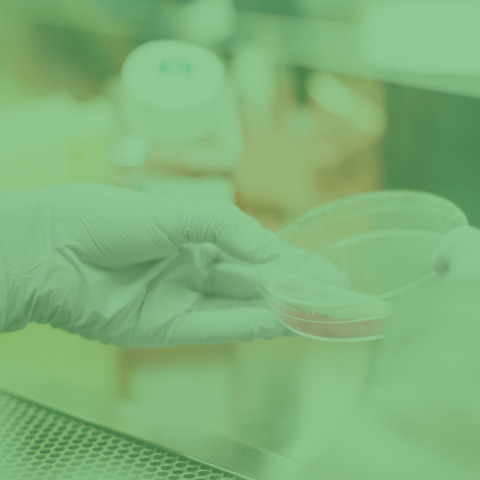
keliones-draudimas_900x900_12_2793-ca0f6f00798e0448b13cc390e98deeb2.jpg

- Titulinis
- PRIVATIEMS
- Produktai
- Asmuo
- Kelionės
Kelionių draudimas
Kam skirtas
Kelionių
draudimas?
Kodėl naudinga draustis pas mus?




Kodėl naudinga draustis pas mus?
Ką
apdraudžiame
Kelionių
draudimu?
Galite pasirinkti papildomas draudimo paslaugas
„Luminor bank“ kredito kortelių turėtojų Kelionių draudimas
Draudžiamojo įvykio atveju praneškite
| Lietuvoje | Užsienyje | |||
| Asistavimo kompanijai „UAB OPS International“ skambindami tel. +370 526 67788 arba rašydami el.paštu info@ops24.eu |
klausimų?
Dažniausiai užduodami klausimai
Sudarant kelionių draudimo sutartį, draudėjas gali būti bet kuris pilnametis fizinis arba juridinis asmuo. Kelionės draudimo sutartį galima sudaryti bet kuriame klientų aptarnavimo skyriuje, taip pat galima pasirinkti paslaugą kelionių draudimas internetu.
Apdraustasis gali būti sutartyje nurodytas draudėjas arba kitas asmuo.
„Compensa“ kelionių draudimas kompensuoja būtinąsias išlaidas, skirtas gydymui, medicininėms priemonėms, ligonio grįžimui į Lietuvą. Papildomai pasirinkus išmoka mokama už nelaimingą atsitikimą, bagažo sugadinimo, netekimo ar vėlavimo, civilinės atsakomybės bei neįvykusios kelionės išlaidas.
Medicininių išlaidų draudimas apima gydymosi ligoninėje, ambulatorinių tyrimų, operacijų, būtinos tvarsliavos, gydytojo paskirtų vaistų, greitosios pagalbos, ligonio ar palaikų transportavimo į Lietuvą, lydinčio asmens, suteiktos pagalbos ir gelbėjimo išlaidas.
Pasirinkti rizikas galima sutartyje nurodžius medicininių išlaidų draudimą.
Pirkti medicininių išlaidų draudimą nėra būtina. Tačiau turint tik Europos sveikatos draudimo kortelę nekompensuojamos privačių medicinos įstaigų, lydinčio asmens, transportavimo ir gelbėjimo išlaidos.
Užsieniečio medicininių išlaidų draudimu galima apdrausti užsienio pilietį, neturintį leidimo gyventi Lietuvoje.
Užsienio piliečius galime apdrausti medicininių išlaidų draudimu.
Užsienio valstybės pilietį galime apdrausti medicininių išlaidų kelionėje draudimu.
Sudarius kelionių draudimo sutartį, draudimas galioja polise nurodytoje teritorijoje, išskyrus Lietuvą ir šalį, kurioje apdraustasis turi pilietybę. Svarbu pasirinkti teritoriją pagal šalį, į kurią vykstama.
Kelionės draudimo sutartis šiuo metu gali būti sudaryta kelionėms, trunkančioms ne ilgiau nei 30 dienų.
Kelionės draudimas galioja bet kurioje teritorijoje, kuri nurodyta draudimo sutartyje.
Sudaryti kelionės draudimo sutartį galima prieš pat kelionę. Jei asmuo jau yra išvykęs į užsienį, draudimas pradeda galioti po 14 dienų. Jei reikalingas neįvykusios kelionės draudimas, sutartis turi būti sudaroma likus ne mažiau kaip 14 dienų iki kelionės.
Šiuo metu galimybės pratęsti sutartį nėra.
Kelionės draudimo kaina (įmokos dydis) priklauso nuo apdraustojo amžiaus, kelionės krypties, planuojamos veiklos kelionės metu, draudimo sumos ir kitų veiksnių.
Draudimo įmoka turi būti sumokėta per vieną kartą, galimybės sumokėti per kelis kartus nėra.
Galite apsidrausti kelionės draudimu, tačiau sporto rizikos draudimo paslauga kainuos papildomai. Draudimo įmokos dydis priklausys nuo pasirinktos sporto šakos.
Kad sudarytumėte kelionės draudimo sutartį, turėsite pateikti tikslius asmens duomenis: vardą, pavardę, asmens kodą bei gyvenamosios vietos adresą, taip pat būtina nurodyti draudimo trukmę, šalį, į kurią vykstama, kelionės maršrutą ir pobūdį bei kitus draudiko prašomus duomenis ir informaciją, reikalingą draudimo rizikai įvertinti.
Draudimo sutartis pradeda galioti sumokėjus draudimo įmoką, tačiau ne anksčiau nei nurodyta draudimo sutartyje ir prasidėjus kelionei (kirtus Lietuvos Respublikos valstybės sieną). Jei sutarties sudarymo metu apdraustasis yra užsienyje, draudimo apsauga įsigalioja po 14 dienų.
Jei jums reikalinga medicininė pagalba, būtina kreiptis į medicinos įstaigą ir vėliau gauti dokumentus, įrodančius patirtas išlaidas. Grįžę iš kelionės kreipkitės dėl patirtų išlaidų atlyginimo.
Taip, bagažą apdrausti galite.
Taip, sporto inventorių apdrausti galite.
Apgailestaujame, tačiau tokios galimybės nėra. Draudimo polise parenkamos teritorijos pagal šalį, į kurią vykstama, pavyzdžiui, Europa ar Europa, įskaitant Turkiją, Egiptą, taip pat visas pasaulis ar visas pasaulis, išskyrus JAV ir pan.).
Galima sudaryti vieną draudimo sutartį. Kiekvienam apdraustam asmeniui draudimo rizikos gali būti parenkamos individualiai.
Jei neišvykote į kelionę, galite pateikti prašymą raštu dėl sutarties nutraukimo. Prašymą galite parašyti bet kuriame mūsų klientų aptarnavimo skyriuje arba atsiųsti elektroniniu paštu info@compensa.lt. Klientų aptarnavimo skyrių sąrašą galite rasti čia. Taip pat laukiami ir kelionių draudimo atsiliepimai.
Norėdami nutraukti draudimo sutartį, turėtumėte parašyti prašymą. Jį galite pateikti elektroniniu paštu info@compensa.lt arba bet kuriame klientų aptarnavimo skyriuje, jų sąrašą galite rasti čia.
Pasibaigus pandemijai Covid-19 infekcija nebėra priskiriama prie nedraudžiamųjų įvykių. Draudžiamojo įvykio atveju už Covid-19 infekciją apdraustajam atlyginsime medicinines gydymo išlaidas draudimo sumos ribose.
Susirgus kelionėje Jums reikėtų susisiekti su asistavimo kompanija, kurios kontaktiniai duomenys yra nurodyti draudimo sutartyje. Asistavimo įmonė padės Jums gauti reikiamą medicininę pagalbą bei išvengti neplanuotų išlaidų.
Kelionių draudimo atveju dėl išmokos turėtumėte kreiptis nedelsdami, bet ne vėliau kaip per 24 valandas nuo žalos atsiradimo dienos, išskyrus atvejus, kai savo lėšomis apmokėjote medicinines paslaugas. Tokiu atveju draudimo bendrovei turėtumėte pranešti per 7 dienas nuo sugrįžimo į Lietuvą.
Registruoti žalą galite trumpuoju numeriu 19111 arba užpildykite pranešimą internetu.
Kelionių draudimo atveju dokumentus turėtumėte pateikti per 7 dienas nuo sugrįžimo į Lietuvą.
Kelionių draudimo atveju turėtumėte pateikti šiuos dokumentus:
- užpildytą pranešimo formą (pildoma internetu arba Jums ją atsiųs kontaktų centro vadybininkai, jei įvykį registruosite trumpuoju numeriu 19111);
- medicininius dokumentus;
- sąskaitas bei dokumentus, patvirtinančius sąskaitų apmokėjimą;
- policijos pažymą, jei nukentėjote užpuolimo ar eismo įvykio metu.
Dokumentus galite pateikti:
- el. paštu zalos@compensa.lt
- registruotu laišku „Compensa“ būstinės adresu Ukmergės g. 280, 06115 Vilnius;
- atvykę į artimiausią žalų administravimo padalinį.
Taip. Elektroninio ryšio priemonėmis sudarytos draudimo sutartys gali būti nutrauktos per 14 dienų nuo jų sudarymo dienos, išskyrus kelionių ir bagažo ar panašias draudimo sutartis, kurių galiojimo terminas trumpesnis negu vienas mėnuo; bei sutartis, kurias kliento prašymu abi šalys yra visiškai įvykdžiusios nepasibaigus sutarties atsisakymo terminui.
„Compensa TeleMed“ – nuotolinių medikų konsultacijų paslauga. Pasirinkę ją, Kelionių rizikų draudimo klientai vos per keletą valandų gali gauti profesionalaus mediko konsultaciją internetu arba telefonu. Jei kelionės metu pablogėja sveikata, apdraustieji gali kreiptis medicininės pagalbos. Nuotolinės konsultacijos metu gydytojas gimtąja kalba gali pateikti nurodymus, kaip elgtis ir netgi paskirti vaistus.
Apdraustasis nuotolinei konsultacijai gali registruotis telefonu +370 659 70000 arba siųsdamas el. laišką (el paštu: medical@easyassistance.lt): konsultacijos teikiamos – vaizdo / telefono skambučiu arba programėlėmis „Viber“, „WhatsApp“; informaciją po registracijos apdrautasis gauna el. laišku; konsultacijos suteikiamos: I-VII; 08:00 – 20:00 (Lietuvos laiku).
Kelionių draudimo sutartis įsigalioja tik tada, kai yra sumokėta draudimo įmoka, bet ne anksčiau nei nurodyta draudimo sutartyje ir tik prasidėjus kelionei (kai apdraustasis kerta Lietuvos Respublikos sieną). Jeigu draudimo sutartis sudaroma jau esant užsienyje, draudimo apsauga įsigalioja po 14 dienų nuo sutarties sudarymo.
Kelionių draudimas negalioja:
- jei kelionė vyksta į Lietuvą ar šalį, kurioje apdraustasis turi pilietybę;
- jei sutartis sudaryta jau būnant užsienyje ir nepraėjo 14 dienų laukimo laikotarpis;
- jei įvykis įvyko dar neprasidėjus draudimo apsaugai arba pasibaigus draudimo terminui;
- kai rizika nėra pasirinkta ir įtraukta į draudimo sutartį (pvz., sporto rizikos, jei nepasirinkta);
- tam tikrais atvejais, kurie nurodyti konkrečiose draudimo sąlygose (pvz., tyčiniai veiksmai, alkoholis, karinės operacijos ir kt.).

.png)
